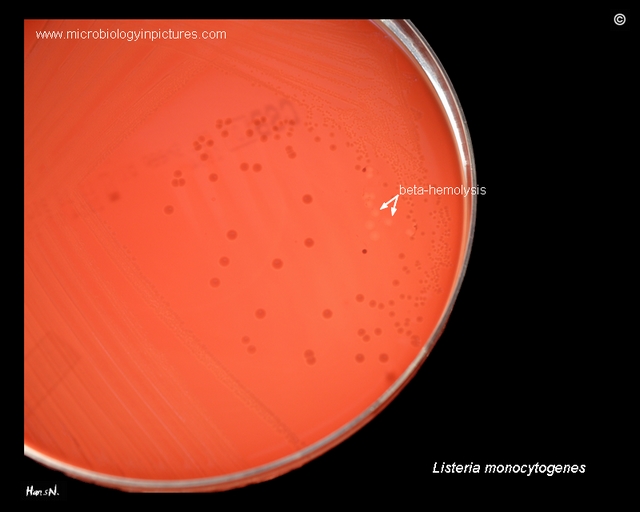

Listeria monocytogenes on blood agar.
Cultivation 48 hours, aerobic atmosphere, 37°C.
Beta-hemolysis on blood agar under the removed colonies of Listeria monocytogenes.
L.monocytogenes is β-hemolytic but many strains produce only narrow zones of hemolysis that frequently do not extend much beyond the edge of the colonies.